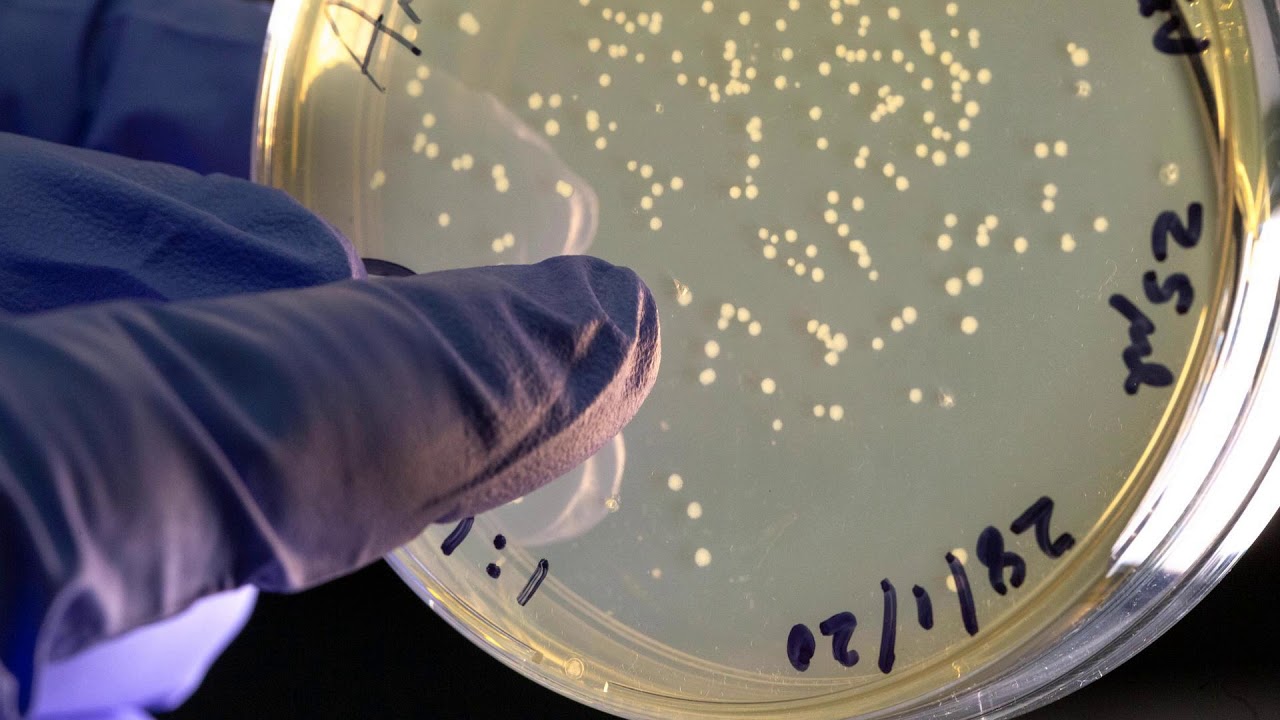

2020 podcasts
The podcast is presented by Gareth Mitchell, a lecturer on Imperial's MSc Science Communication course. He’s also a longstanding BBC presenter and reporter. Gareth is joined each month by our roving reporters in the Communications Division.
If you have feedback that you'd like to share or ideas for future editions, we'd love to hear from you; please contact Gareth Mitchell.
You can also find the podcasts on most major platforms, including YouTube, Apple Podcasts, Stitcher and Spotify.
Check out other podcasts produced across the College in our podcast directory.
2020 archive
- Child health, Bionic Olympics, and a better Christmas dinner
- Statin side effects, vaccine latest and pandemic politics
- Pandemic mental health, hidden strengths and severe morning sickness
- Maths marvel, COVID in children and cooking with hyperfoods
- COVID-19 vaccine trials latest and privacy in contact tracing
- COVID-19 vaccine trials, neurodiversity in focus, and poet in residence
- Vaccine production, safety on public transport, and emerging economies
- Britain’s brains, COVID-19 at the GP, and a green economic recovery
- COVID-19 vaccine development, patient data and isolation diaries
- Counting coronavirus, a baby food entrepreneur and designing for Mars
- Coronavirus vaccine, global progress report and fighting racism
- Drug policy, Australian megafires and London fatbergs
Child health, Bionic Olympics, and a better Christmas dinner
In this edition: A new child health centre opens, assistive technologies at the Cybathlon, and healthier Christmas food for you and the planet.
Download the complete podcast (mp3)
OR listen to individual chapters:
News: Looking back at 2020 – Our podcast team share the most interesting facts they’ve learned on the job this year – from how much water it takes to make a pair of jeans to how fungus can be used to make a leather alternative.
Launch of a new child health centre – We catch up with the Centre for Paediatrics and Child Health's inaugural Director, Professor Andy Bush, about priorities for research into child health, working with local communities, and how the pandemic has affected the capacity for care.
The ‘Bionic Olympics’ – We talk to Professor Aldo Faisal about the Cybathlon, where differently abled athletes compete using the latest assistive technologies, and how his work using sensors to understand real-world learning can help in rehabilitation.
Levelling up Christmas dinner – How can we enjoy the holidays but also make our Christmas dinner better for the planet and ourselves? Aygul Dagbasi tells us more.
(16 December)
Statin side effects, vaccine latest and pandemic politics
In this edition: The nocebo effect of statins, the latest on Imperial’s COVID-19 vaccine and a former PM talks pandemic.
Download the complete podcast (mp3)
OR listen to individual chapters:
News: Gut problems linked to depression, and a new test for Chagas disease – We find how people with inflammatory bowel conditions are often diagnosed with depression before their bowel diagnosis, and discover a new test that can differentiate between the different strains of Chagas disease.
The nocebo effect of statins – We learn from Dr James Howard about his study that found some people report side effects whether they are taking statins or just placebo pills, showing the startling ‘nocebo effect’ that can stop people taking vital medicines despite doing them no harm.
The state of COVID-19 vaccines – We speak to Professor Robin Shattock, who is leading Imperial’s vaccine effort, about the current state of play and how he feels about anti-vaccine sentiments.
You can also listen to an extended version of this interview.
Neil Ferguson and Tony Blair talk pandemic – The Director of Imperial’s J-IDEA institute, Professor Neil Ferguson, talks to former PM Tony Blair about the scientific and political response to the pandemic.
You can watch the full interview on the J-IDEA YouTube channel.
(25 November)
Pandemic mental health, hidden strengths and severe morning sickness
In this edition: Exploring pandemic mental health, comparing spaceflight and frontline NHS work, and linking severe morning sickness with depression.
Download the complete podcast (mp3)
OR listen to individual chapters:
News: The toll of the first wave and bringing the Festival online – We discover how the first wave of the COVID-19 pandemic affected deaths from all causes, and look forward to the Great Exhibition Road Festival moving online with the launch of a new art project.
Youth mental health during the pandemic – We speak to Dr Lindsay Dewa, who is part of a project to find out how young people coped during the COVID-19 lockdown, and whether their coping strategies have changed over time.
Comparing spaceflight and surgery – Astronaut Helen Sharman chats to trainee surgeon Dr Derek Yeung, comparing notes on the challenges and triumphs of spaceflight and working on the frontline of the COVID-19 pandemic.
This is an excerpt from the Hidden Strengths podcast series, created by PanSurg, where healthcare staff share their experiences of adversity and perseverance with key figures.
Extreme morning sickness and depression – We talk to Nicola Mitchell-Jones, who recently found that hyperemesis gravidarum – an extreme form of morning sickness – often causes depression during and after pregnancy, which is rarely followed up.
(21 October)
Maths marvel, COVID in children and cooking with hyperfoods
In this edition: A $3m-prizewinning mathematician, a new project into how children transmit COVID-19, and recipes with anti-cancer properties.
Download the complete podcast (mp3)
OR listen to individual chapters:
News: Hints of life on Venus and fungal leather – We discuss the discovery of a molecule possibly linked with life in the clouds of Venus, and whether leather could be replaced by a more eco-friendly material made from fungus.
Millionaire mathematician – We catch up with Professor Martin Hairer, winner of the $3m Breakthrough Prize in Mathematics, hearing about his field of work, his inspiration and what he’ll spend that prize money on.
You can also listen to an extended version of this interview.
How infectious are children with COVID-19? – As schools restart, we talk to the leader of a new research project into how children transmit the virus, following diagnosed children to see if they can cause outbreaks.
You can also listen to an extended version of this interview.
Cooking with hyperfoods – We meet the researcher and chef behind a new cookbook – Hyperfoods – that includes recipes packed with ingredients containing anti-cancer molecules, discovered using the power of people’s smartphones. You can get the recipes for free on the Kitchen Theory website.
(23 September)
COVID-19 vaccine trials latest and privacy in contact tracing
In this edition: Results of the COVID-19 vaccine animal trials and the latest news from the human trials, plus privacy in contact tracing apps.
Download the complete podcast (mp3)
OR listen to individual chapters:
News: Coronavirus in the community and Lates online – We find out the latest results from the REACT study, analysing past and present COVID-19 infections, and look forward to the program of online Imperial Lates events, connecting the public to our research.
COVID-19 vaccine animal trials – We hear about encouraging results from the vaccine trial on mice, and what it means for a vaccine to be ‘effective’.
This feature is an excerpt from 'Never Lick the Spoon' – a podcast from Imperial's Institute for Molecular Science and Engineering.
COVID-19 vaccine Q&A – The public put questions to members of the vaccine team, covering manufacture, the latest news from the human trials, and whether we could soon do away with masks and social distancing.
You can hear the full Q&A, and others on different coronavirus topics, on our Let’s talk about COVID-19 pages.
Privacy in contact tracing – A vital tool in combatting the COVID-19 pandemic is contact tracing, with a new app due to be launched. But what are the privacy concerns of such apps, and can they be overcome for the greater good?
Researcher Andrea Gadotti will be taking part in a Reddit Ask Me Anything on 2 September 2020. Check the Lates website for more information.
(19 August)
COVID-19 vaccine trials, neurodiversity in focus, and poet in residence
In this edition: A participant in Imperial’s COVID-19 vaccine trial, a professor who set up a neurodiversity network, and our new poet in residence.
Download the complete podcast (mp3)
OR listen to individual chapters:
News: AI and COVID-19 treatments, plus extreme driving – We find out about a new trial using artificial intelligence to improve ventilation for very ill COVID-19 patients, and what tracking the body and eye movements and brain waves of a Formula E driver can tell us about expertise.
Taking part in a COVID-19 vaccine trial – We catch up with a participant in Imperial’s COVID-19 vaccine trial after she receives her first dose, to see how she feels and why she decided to take part.
Neurodiversity network – We talk to Professor Sara Rankin, who was only diagnosed with dyslexia and dyspraxia as an adult, about her journey and why she helped set up a network for neurodiverse staff and students at Imperial and partner organisations in South Kensington.
Professor Rankin has also produced a series of Lockdown Lessons, talking to scientists at Imperial that have rapidly responded to the COVID-19 pandemic.
Poet in residence – We talk to Imperial’s new poet in residence Dan Simpson and researcher Dr Ans Vercammen about the poem they are working on together and how art and science really aren’t that different.
Their final poem will be unveiled at the Imperial Lates Online: Back to Nature, running online from 27 July to 2 August. You can also listen to Dan’s crowdsourced Back to Nature poem and some more of his quick-fire haikus.
(22 July)
Vaccine production, safety on public transport, and emerging economies
In this edition: How to make a billion COVID-19 vaccines, why women feel unsafe on public transport, and how emerging economies fare under COVID-19.
Download the complete podcast (mp3)
OR listen to individual chapters:
News: Reacting to George Floyd’s death – We speak to Sarah Essilfie-Quaye and Dr Wayne Mitchell from Imperial as One, an advisory group made up of Black, Asian and Minority Ethnic (BAME) staff, about the response to George Floyd’s death and what should be done to tackle racism.
You can also hear an extended version of this interview.
Scaling up vaccine production – Once a COVID-19 vaccine has been successful in clinical trials, how can we make more than a billion doses in a matter of months? We hear about the challenges and how we might overcome them.
This feature is an excerpt from 'Never Lick the Spoon' – a monthly podcast from Imperial's Institute for Molecular Science and Engineering.
How safe do you feel on public transport? – A new study shows how women are more likely to feel unsafe on public transport. The effect is not just simple fear but can affect their working lives and career opportunities; so how can we design safer transport systems? Laila Ait Bihi Ouali explains.
COVID-19’s impact on emerging economies – Emerging economies like India face different challenges in lockdowns, but also potentially have some real opportunities for recovery. We find out more with economics professor Tarun Ramadorai.
You can also listen to an extended version of this interview.
(17 June)
Britain’s brains, COVID-19 at the GP, and a green economic recovery
In this edition: Britain’s intelligence and mental health, COVID-19’s impact on primary care, and a sustainable economic recovery after the pandemic.
Download the complete podcast (mp3)
OR listen to individual chapters:
News: Compression stockings and tackling global challenges online – We discover how compression stockings do not lower your risk of developing blood clots after surgery, and how an online platform is bringing together scientists and innovators to solve grand challenges like COVID-19 or climate change.
Measuring Britain’s intelligence and mental health – We meet the makers of the Great British Intelligence Test, who are now turning their attention to the population’s mental health during the pandemic.
How COVID-19 impacts GP services – We talk to a researcher and practising GP about how services have changed – such as more phone and video interviews – and what people can do to look after themselves.
A green economic recovery – We hear about a report that suggests climate-friendly investment would boost the economy in the short and long term following the COVID-19 pandemic, and other ways the future could, and should, be greener.
(20 May)
COVID-19 vaccine development, patient data and isolation diaries
In this edition: We hear from researchers working on a COVID-19 vaccine and with patient samples, and how students are coping in isolation.
Download the complete podcast (mp3)
OR listen to individual chapters:
News: University Challenge win and neutrino discovery – We celebrate Imperial’s spectacular University Challenge win and discover how neutrinos may hold the key to why the universe is made up of matter rather than antimatter.
On the frontlines of COVID-19 vaccine development – We speak to Dr Anna Blakney about what it’s like to work on a vaccine the whole world is waiting for.
This feature is an excerpt from 'Never Lick the Spoon' – a monthly podcast from Imperial's Institute for Molecular Science and Engineering.
Understanding and treating COVID-19 – We hear from Professor Peter Openshaw how thousands of samples from COVID-19 patients across the country are already providing valuable insights into the disease, including who seems to get it worse, and how the disease progresses.
Isolation diaries from around the world – We hear from the producers of a video capturing snippets from Imperial students now scattered across the world.
(22 April)
Counting coronavirus, a baby food entrepreneur and designing for Mars
In this edition: We hear from people tracking the spread of COVID-19, making better baby food, and designing for a move to Mars.
Download the complete podcast (mp3)
OR listen to individual chapters:
News: Bee brains and tracking fireballs – We learn how certain pesticides are impairing baby bee brains, and how a network of cameras and volunteers across the UK are tracking fallen stars.
Counting coronavirus – How fast and how widely is COVID-19 spreading? We hear from epidemiologist Professor Azra Ghani about how they make sure they have the right data to build their models of the outbreak, and what that means for how we mitigate the spread.
Baby food entrepreneur – Business School alum Nadine Hellmann, who developed her idea for a new kind of baby food at Imperial, gives us tips on starting a business from scratch while studying.
Designing for Mars – Would you move to Mars? What do we need to do to make the move possible? Imperial scientists and students provide possible solutions, from space weather monitors to new materials for shoes.
(18 March)
Coronavirus vaccine, global progress report and fighting racism
In this edition: Join the race to develop a Covid-19 vaccine, check in on the Sustainable Development Goals, and discover how to argue with a racist.
Download the complete podcast (mp3)
News: Solar Orbiter lift-off and cutting contrails – We follow Imperial’s instrument aboard the Solar Orbiter spacecraft as it takes its first data in space, and find out how altitude changes of just 2000 feet can cut the environmental impact of aeroplane contrails.
The race to develop a Covid-19 vaccine – We meet the Imperial team, headed by Professor Robin Shattock, developing a new kind of vaccine that could be available to people far faster than in previous viral outbreaks.
Progress in the Sustainable Development Goals – Dr David Nabarro, co-director of Imperial’s Institute of Global Health Innovation, helped set up the UN’s Sustainable Development Goals. He tells us how much progress we’ve made, and where there is still work to be done.
How to argue with a racist – Geneticist and science communicator Dr Adam Rutherford explains how science has been misused to justify bigotry and racism, and how we can fight back.
(19 February)
Drug policy, Australian megafires and London fatbergs
In this edition: We discuss whether drug policy is working, why Australia is experiencing megafires, and what can be done about fatbergs.
Download the complete podcast (mp3)
OR listen to individual chapters:
News: Miscarriage and PTSD, and a remarkable refugee professor – We find out how many women experience post-traumatic stress disorder after miscarriage, and learn about the remarkable life of a venerable maths professor.
Is drug policy working? – Former government adviser Professor David Nutt tells us how restrictions on tobacco are working, but that hard drugs policies have in some cases made problems worse, and what can be done.
Why is Australia facing megafires? – We find out what’s making Australia’s wildfires so bad they have become megafires, including the factors involved in their spread and how much climate change might be to blame.
The big, gross problem of fatbergs – Huge accumulations of fat and unflushable material can block drains and city sewers, but how do we work out the best way to prevent them and remove them?
This feature is an excerpt from 'Never Lick the Spoon' – a monthly podcast from Imperial's Institute for Molecular Science and Engineering.
(22 January)